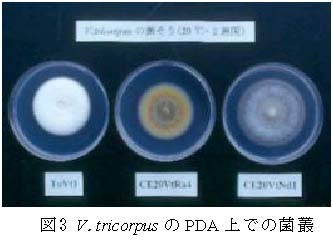

[要約]
千葉県内で栽培されていたアネモネ、ラナンキュラス、デルフィニウム、ニゲラ、トマトおよび市販のジャガイモから、植物検疫上特定重要病害に指定されていたV.tricorpusが分離された。分離菌の病原性はないか、または非常に弱く、栽培上問題とならない。
| [キーワード] | アネモネ、ラナンキュラス、デルフィニウム、ニゲラ、トマト、ジャガイモ、Verticillium tricorpus、病原性 |
| [担当] | 千葉農総研 暖地園芸研究所 環境研究室 |
| [連絡先] | 0470-22-2603 |
| [区分] | 関東東海北陸農業・関東東海・病害虫 |
| [分類] | 行政・普及 |
[背景・ねらい]
千葉県で作付けされていたアネモネ、ラナンキュラス、デルフィニウム、ニゲラ、トマトおよび市販のジャガイモからVerticillium属菌が分離された。分離菌の特徴は、本邦への侵入を警戒する特定重要病害虫に指定されているV.tricorpusに類似していたため、さらに詳しい検討を行う。
[成果の内容・特徴]
[成果の活用面・留意点]
[成果の概要]

[その他]
| 研究課題名 | :数種キンポウゲ科植物およびトマトから分離された特定重要病害 Verticillium tricorpus |
| 予算区分 | :県単 |
| 研究期間 | :2000~2002年度 |
| 研究担当者 | :海老原克介、植松清次(千葉農総研)、君島悦夫(横浜植防)、森脇丈治(農環研)、酒井宏(群馬園試) |
| 発表論文等 | :1) 海老原ら(1999) 日本植物病理学会報 65(3):399 2) 海老原ら(2000) 日本植物病理学会報 66(3):274 |
侵入病害
球根、種子の輸入量
君島さんの文献
侵入病害虫の数
植松さんの文献